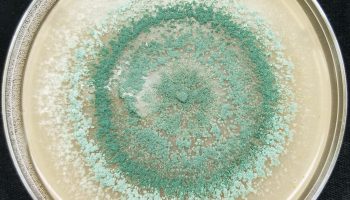

Découvrez les articles du blog du Jardinier Français, votre jardinerie à Nîmes !
Dans notre blog, vous trouverez plein de conseils et d’astuces pour bien entretenir votre jardin au naturel ! Profitez de toute l’expertise de votre jardinerie écologique à Nîmes dans le Gard.

L’importance des Trichoderma pour vos cultures de plantes
Lire la suiteLe Jardinier Français : nouveau compte sur Instagram !
Lire la suiteL’engrais biologique
Les avantages de l'engrais organique
Lire la suiteLes engrais verts
Lire la suiteLe lombri-compost
Lire la suiteDynamisez votre eau !
Lire la suiteLa préparation automnale du potager
Lire la suiteLitière Forestière Fermentée : Qu’est ce que c’est ?
Lire la suiteLes plants potagers sont arrivés !
Lire la suite

Vous désirez en savoir davantage sur notre boutique à Nîmes dans le Gard ? Vous avez besoin de conseils pour lancer votre projet de jardinage au naturel ? Vous recherchez de l’aide pour nourrir au mieux votre sol ou dénicher le meilleur engrais biologique ? Vous voulez mettre en place un système de filtration de l’eau pour vos espaces verts, ou trouver des graines de qualité pour vos cultures ? Notre jardinerie est là pour vous aider ! Vous pouvez pour cela nous contacter en appelant le 04 66 36 76 71, ou nous envoyer un petit message à l’adresse suivante : contact@jardinerie-ecologique.fr. Nous vous répondrons dans les plus brefs délais !